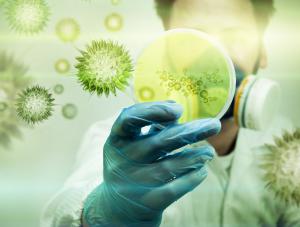

Około dwóch milionów przypadków zachorowań na raka rocznie jest wynikiem infekcji – twierdzą naukowcy. Wynika z tego, że co szósty pacjent mógłby w ogóle nie zachorować. Na jakie schorzenia warto zwracać uwagę?
Około dwóch milionów przypadków zachorowań na raka rocznie jest wynikiem infekcji – twierdzą naukowcy. Wynika z tego, że co szósty pacjent mógłby w ogóle nie zachorować. Na jakie schorzenia warto zwracać uwagę?more
Home » informacje » Infekcja może skończyć się nowotworem. Na co uważać?
Autor: Unknown on wtorek, 13 maja 2014
Około dwóch milionów przypadków zachorowań na raka rocznie jest wynikiem infekcji – twierdzą naukowcy. Wynika z tego, że co szósty pacjent mógłby w ogóle nie zachorować. Na jakie schorzenia warto zwracać uwagę?
Około dwóch milionów przypadków zachorowań na raka rocznie jest wynikiem infekcji – twierdzą naukowcy. Wynika z tego, że co szósty pacjent mógłby w ogóle nie zachorować. Na jakie schorzenia warto zwracać uwagę?2014 All Rights Reserved Informacje fakty.
» Informacje fakty: Infekcja może skończyć się nowotworem. Na co uważać?
{ 0 komentarze... » Infekcja może skończyć się nowotworem. Na co uważać? read them below or add one }
Prześlij komentarz